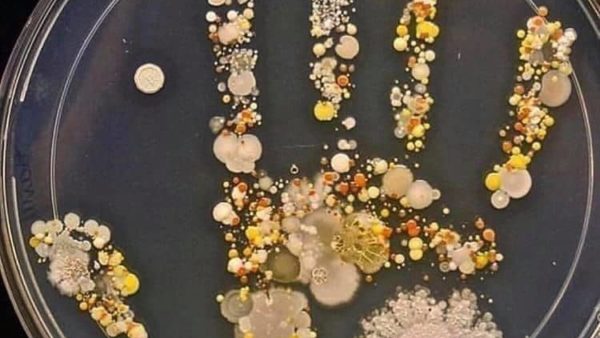

Tracking Body Temperature
Tracking Body Temperature
Temperature Too Cool?
 What might mind, body, and spirit care look like? To each person it will look a little different because of our individual uniqueness.
What might mind, body, and spirit care look like? To each person it will look a little different because of our individual uniqueness.